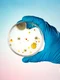
Bacterii_shutterstock 1923502868 (1) jpg
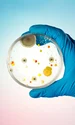
Bacterii_shutterstock 1923502868 (1) jpg

Vești bune. Ajutor de la stat pentru cumpărarea medicamentelor inovatoare. Acces mai ușor la radioterapie pentru pacienții cu cancer
Guvernul României a aprobat recent o serie de măsuri semnificative destinate îmbunătățirii sistemului de sănătate din țară. Aceste măsuri vizează, în mod special, pacienții bolnavi de cancer și se concentrează pe facilitarea accesului la tratamente inovatoare și servicii de radioterapie. De asemenea, Guvernul a adoptat măsuri menite să protejeze consumatorii și să sprijine educația prin suplimentarea numărului de cadre didactice.

Acces mai ușor la radioterapie pentru pacienții cu cancer
Una dintre măsurile de bază anunțate de premierul Marcel Ciolacu vizează îmbunătățirea accesului pacienților bolnavi de cancer la servicii de radioterapie. Conform noilor reglementări, aceste servicii vor fi decontate de stat, ceea ce va reduce povara financiară asupra pacienților și familiilor lor. „În domeniul sănătăţii, aprobăm măsuri pentru bolnavii de cancer prin acces la servicii de radioterapie decontate”, a declarat Ciolacu.
Sprijin pentru medicamente inovatoare și îngrijiri paliative
Guvernul a anunțat, de asemenea, un ajutor de stat destinat pacienților care au nevoie de medicamente inovatoare. Această măsură vine în sprijinul celor care urmează tratamente de ultima generație, care sunt adesea costisitoare. În plus, va fi completat Programul Național de Îngrijiri Paliative, care va acoperi îngrijirile atât în unități cu paturi, cât și la domiciliu și în ambulatoriu. „Completăm şi Programul naţional de îngrijiri paliative prin casele de asigurări de sănătate”, a adăugat premierul.
Un alt aspect important al ședinței Guvernului a fost aprobarea unui ordin ANPC care vizează sancționarea comercianților care practică reducerea gramajului produselor fără a modifica prețul. Acest ordin, care urmează să fie publicat în Monitorul Oficial, are ca scop protejarea consumatorilor de formele de înșelăciune comercială. „Este gata şi ordinul preşedintelui ANPC de stopare a fenomenului prin care comercianţii scad gramajul produselor, dar lasă preţurile la fel. Această formă de înşelăciune împotriva consumatorului se încheie astăzi”, a declarat Ciolacu.
Suplimentarea cadrelor didactice în învațământul preuniversitar
Pe lângă măsurile din domeniul sănătății, Guvernul a decis să sprijine și educația prin suplimentarea numărului de posturi în învățământul preuniversitar. Vor fi angajate aproximativ 7.800 de cadre didactice, dintre care o parte vor fi dedicate îngrijirii copiilor cu nevoi speciale. „Majorăm cu 7.800 numărul de posturi în învăţământul preuniversitar de stat. Creşterea este necesară pentru a asigura dreptul la educaţie şi integrare în cazul unui număr tot mai mare de copii cu cerinţe speciale în învăţământul de masă”, a subliniat premierul.